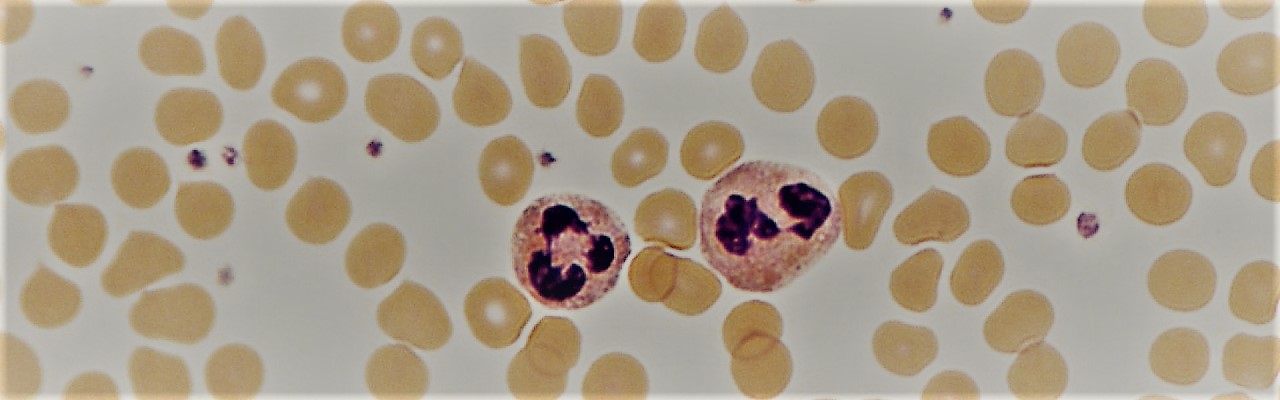

Mediante la alteración de ciertas hormonas implicadas en la regulación de la función inmunitaria, el exceso de cloruro de sodio inhibe la respuesta de defensa ante infecciones bacterianas.
Por Marta Pulido Salgado
Aunque algunas evidencias sugieren que la sobreingesta de sal a través de la dieta potencia la respuesta del sistema inmunitario, sobre todo en la piel, científicos del Hospital Universitario de Bonn, en Alemania, liderados por Christian Kurts, han dado con un resultado que contradice estas observaciones. Según su artículo, publicado por la revista Science Translational Medicine, el exceso de cloruro de sodio comprometería la respuesta antibacteriana de los inmunocitos, y en particular de los neutrófilos. Sin embargo, dicho efecto sería indirecto.
Los experimentos, realizados en ratones previamente inoculados con bacterias Eschericha coli a fin de que desarrollaran pielonefritis, una infección de la uretra que también puede afectar a los riñones, mostraron que el consumo de alimentos ricos en sal favorecía el crecimiento de los microorganismos patógenos. Asimismo, el análisis del tejido renal reveló deficiencias notables en la capacidad de los neutrófilos, un tipo de glóbulos blancos, para fagocitar y eliminar las bacterias.
Pero, ¿mediante qué mecanismo el cloruro de sodio altera la función inmunitaria? La respuesta a dicha pregunta se halla en el modo en que los riñones excretan el exceso de sal. En este caso, el equilibrio osmótico entre sodio y agua, esencial para el correcto filtrado de la sangre, se altera. En consecuencia, y a fin de corregir este desequilibrio, el tejido renal sustituye el elemento químico por la proteína urea. Ello amortiguaría la acción de los neutrófilos, pero no constituiría el factor determinante.
De acuerdo con los resultados, para eliminar la sal, el organismo reduciría la síntesis de la hormona aldosterona, que ocurre en la glándula suprarrenal localizada sobre los riñones. La disrupción del ciclo hormonal y la acumulación de los precursores de la aldosterona inhibirían, de forma directa, la función bactericida de los neutrófilos.
La inclusión en el estudio de voluntarios sanos permitió corroborar los resultados en humanos. En concreto, tras seguir una dieta rica en sal, equivalente a dos raciones de comida rápida por día, a lo largo de una semana, los autores aislaron los neutrófilos de la sangre de los participantes y observaron alteraciones parecidas a las detectadas en los roedores.
Para Kurts y sus colaboradores, las conclusiones de la investigación postulan que el consumo de cloruro de sodio en exceso no siempre promovería la respuesta proinflamatoria del sistema inmunitario, hipótesis ampliamente aceptada hasta la fecha. Por lo tanto, aconsejan revisar las recomendaciones sobre el consumo diario de sal y avisan que la dieta occidental, rica en este condimento, podría agravar las infecciones bacterianas.
Referencia: «A high-salt diet compromises antibacterial neutrophil responses through hormonal perturbation», de K. Jobin et al., en Science Translational Medicine; 12 (536):eaay3850, publicado el 25 de marzo de 2020.
Publicado originalmente en Investigación y Ciencia